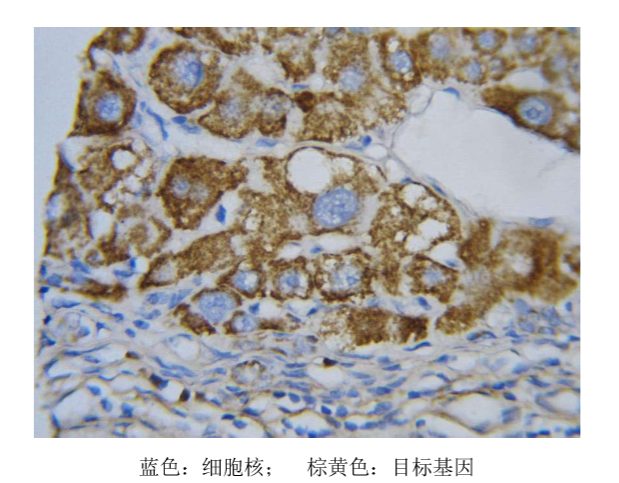
产品细节图片3

相关产品推荐更多 >
万千商家帮你免费找货
0 人在求购买到急需产品
- 详细信息
- 文献和实验
- 技术资料
- 库存:
99999
- 英文名:
CISH(短链)Kit
- 保质期:
1年
- 供应商:
广州伯信生物科技有限公司
- 保存条件:
4℃、-20℃
- 规格:
100T
伯信生物建立了DIG原位杂交探针(ISH Probe)制备平台,承接定制DIG原位杂交试剂盒业务,可根据客户需要进行个性化定制。该试剂盒主要用于检测样本中目的基因的表达量及表达位置,可用于组织切片(石蜡切片/冰冻切片)、细胞爬片及染色体片等的检测。
伯信生物DIG原位杂交试剂盒,自上市以来深受广大科研用户的欢迎和肯定,为中国科学院、中山大学医学院及附属医院、南方医科大学医学院及附属医院、香港大学、北京大学医学部及附属医院、东南大学医学院、江西农业大学、华中科技大学同济医学院等国内知名科研院所、医疗机构及跨国生物企业等近千家用户提供了优质的服务。同时经过多年的积累,伯信生物拥有强大的原位杂交技术团队,为客户在试剂盒使用中遇到的各种问题给予技术支持和解答。
目前公司拥有库存现货试剂盒种类已达近千种:其中mRNA 约1100种;microRNA 约 500种;种属涵盖人、大小鼠、兔、猪、鸡、细菌、昆虫类等等。

实验原理:
待检测的细胞或组织切片上的靶核酸与所用的核酸探针同源互补,二者经变性—退火—复性,即可形成靶核酸与核酸探针的杂交体。将核酸探针的某一种核苷酸标记上半抗原DIG,最后通过免疫组织化学法对半抗原定位,间接地显示探针与靶核酸形成的杂交体,从而对靶核酸进行定性、半定量及相对定位分析的一种实验方法。
技术流程:

结果实例:
产品特点:
1、安全、快速、重复性好;
2、特异性100%,灵敏度超过90%;
3、探针性能稳定,低温保存两年以上;
4、操作简单,定位精准,无实验污染;
5、根据客户需求定制个性化探针。
风险提示:丁香通仅作为第三方平台,为商家信息发布提供平台空间。用户咨询产品时请注意保护个人信息及财产安全,合理判断,谨慎选购商品,商家和用户对交易行为负责。对于医疗器械类产品,请先查证核实企业经营资质和医疗器械产品注册证情况。
文献和实验- Tao X, Li Y, Fan S, Wu L, Xin J, Su Y, Xian X, Huang Y, Huang R, Fang W, Liu Z. Downregulation of Linc00173 increases BCL2 mRNA stability via the miR-1275/PROCA1/ZFP36L2 axis and induces acquired cisplatin resistance of lung adenocarcinoma. J Exp Clin Cancer Res. 2023 Jan 10;42(1):12. IF=11.300.
- Li F, Yang J, Li Y, Tan Z, Li H, Zhang N. Long non-coding RNA FENDRR suppresses cancer-associated fibroblasts and serves as a prognostic indicator in colorectal cancer. Transl Oncol. 2023 Oct;36:101740. IF=5.000.
- Han W, Shi CT, Chen H, Zhou Q, Ding W, Chen F, Liang ZW, Teng YJ, Shao QX, Dong XQ. Role of LncRNA MIR99AHG in breast cancer: Bioinformatic analysis and preliminary verification. Heliyon. 2023 Sep 4;9(9):e19805. IF=4.000.
- Xu Q, Lu X, Li J, Feng Y, Tang J, Zhang T, Mao Y, Lan Y, Luo H, Zeng L, Xiang Y, Hu L, Zhang Y, Li Q, Deng L, He X, Tang B, Mao X, Zeng D. Fusobacterium nucleatum induces excess methyltransferase-like 3-mediated microRNA-4717-3p maturation to promote colorectal cancer cell proliferation. Cancer Sci. 2022 Nov;113(11):3787-3800. IF=5.700.
- Lin Y, Zhou Z, Xie L, Huang Y, Qiu Z, Ye L, Cui C. Effects of miR-939 and miR-376A on ulcerative colitis using a decoy strategy to inhibit NF-κB and NFAT expression. Eur J Histochem. 2022 Feb 15;66(1):3316. IF=2.000.
- Wang S, Lin Y, Li F, Qin Z, Zhou Z, Gao L, Yang Z, Wang Z, Wu B. An NF-κB-driven lncRNA orchestrates colitis and circadian clock. Sci Adv. 2020 Oct 14;6(42):eabb5202. IF=13.600.
- Wu Z, Luo J, Huang T, Yi R, Ding S, Xie C, Xu A, Zeng Y, Wang X, Song Y, Shi X, Long H. MiR-4310 induced by SP1 targets PTEN to promote glioma progression. Cancer Cell Int. 2020 Dec 17;20(1):567. IF=5.800.
- Tang T, Wang LX, Yang ML, Zhang RM. lncRNA TPTEP1 inhibits stemness and radioresistance of glioma through miR‑106a‑5p‑mediated P38 MAPK signaling. Mol Med Rep. 2020 Dec;22(6):4857-4867. IF=3.400.
标记DNA探针 如果您有足够量的高纯度模板,建议您采用随机引物标记方法的DIG High Prime DNA Labeling and Detection Starter Kit I 和II。这两个试剂盒包含了标记、封闭、杂交和检测所需要的所有试剂,是真正意义上的一站式服务的试剂盒。二者之间的差别在于检测方法的不同:Starter Kit
子序列。 对于原位杂交的应用,为了更好地进行杂交反应的质控,建议在制备反义链探针的同时,也制备正义链的探针,用作杂交实验的阴性对照。在原位杂交实验前,首先通过Northern blots实验验证探针的有效性和目标转录子在不同样本中的表达模式,有助于简化后续原位杂交实验的优化流程和结果解释。 模板制备和探针标记 以地高辛(DIG)的探针标记方法为例,罗氏DIG Northern Starter Kit的操作
。 对于原位杂交的应用,为了更好地进行杂交反应的质控,建议在制备反义链探针的同时,也制备正义链的探针,用作杂交实验的阴性对照。在原位杂交实验前,首先通过Northern blots实验验证探针的有效性和目标转录子在不同样本中的表达模式,有助于简化后续原位杂交实验的优化流程和结果解释。 模板制备和探针标记 以地高辛(DIG)的探针标记方法为例,罗氏DIG Northern Starter Kit的操作指南中建议,如果直接通过PCR方法











